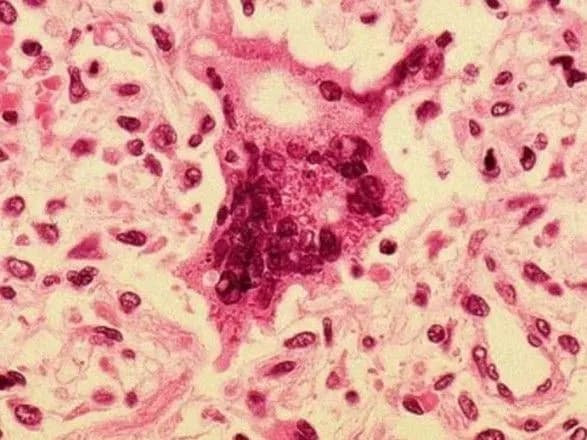
На Прикарпатті майже 40% хворих на кір не мали щеплення

На Прикарпатті майже 40% хворих на кір не мали щеплення
Київ • УНН
КИЇВ. 12 лютого. УНН. За статистикою в Івано-Франківській області 39,2% хворих на кір не мали щеплення. Такі дані опублікував обласний лабораторний центр Міністерства охорони здоров'я, передає УНН.
Станом на 7 лютого у області 1052 особи звернулись з підозрою на кір, в тому числі 765 дітей віком до 17 років, що становить 72%.
Показник захворюваності у Івано-Франківській області складає 76,5 на 100 тис. населення. Серед дітей найбільша захворюваність у вікової групи 5-9 років, що складає 33,3%.
Всього госпіталізовано 637 осіб, в тому числі 411 дітей до 17 років.
Серед захворілих – 20,7% щеплені згідно Календаря щеплень (отримали 2 дози), 17,8% - отримали одне щеплення, 39,2% - не щеплені, у решти – 22,3% відсутні дані про щеплення.
Лабораторний центр попереджає, що зупинити поширення хвороби може лише вакцинація.
Раніше УНН повідомляв, що в Мукачеві дітям, які не отримали планову вакцинацію, заборонять відвідувати школи.
Нагадаємо, серед усіх європейських країн найвищий рівень захворюваності на кір в Україні.